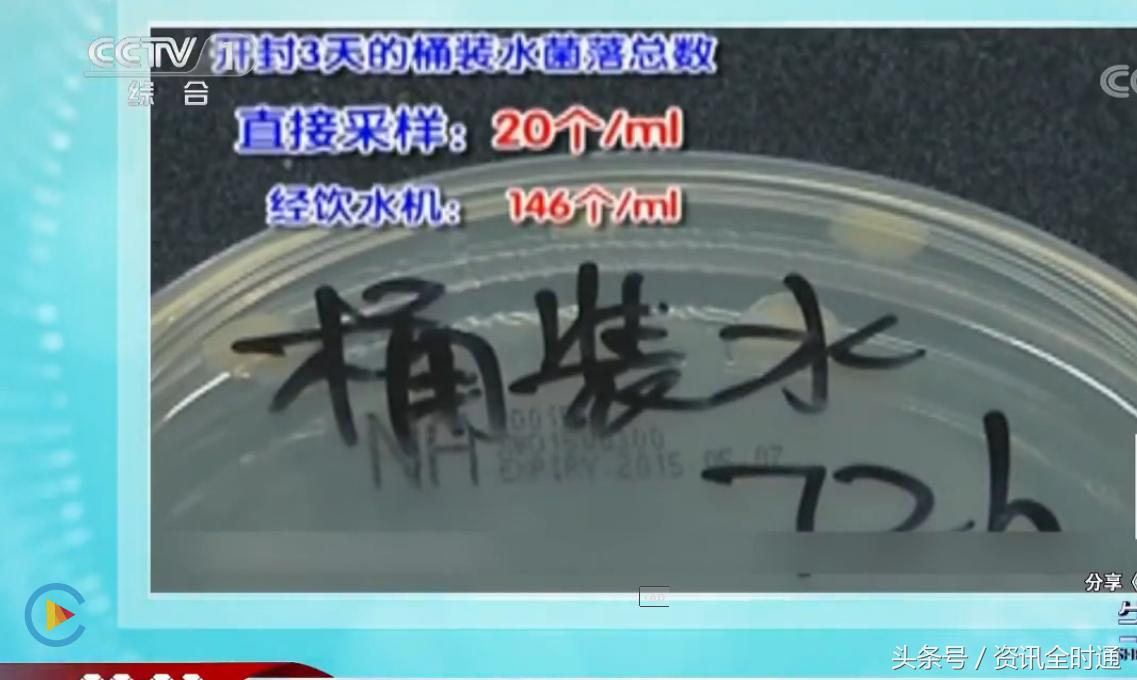
怎么消除传统饮水机细菌问题,饮水机使用时间长了怎么清理干净

现在大家不管是生活还是工作中一般都喝桶装水。正常来说大多桶装水的保质期在一个月。一般打开之后三天内喝完是比较好的,三天以上桶装水的细菌就会明显增多。但是一般三口之家白天基本上班,一桶水的饮用时间大都在三天以上。那该如何避免桶装水的细菌过多那?

研究人员从市场上买来两桶同品牌的矿泉水,一同打开静止在一旁,一同放在新买的饮水机上,连续三天对两桶水的水样进行检测,令人意外的是到了第三天,饮水机上的桶装水细菌数量达到了每毫升146个,超过了国家标准,成为不合格的桶装水。

而开封静止的桶装水细菌总数仅为20个。可见饮水机才是滋生细菌的根本!那马我们改如何清洗饮水机那?
首先先拔掉插座,不要带电操作奥,然后把饮水机内胆里面的水都清理干净。

第二步,把白醋导入饮水机的内胆中。

第三步,加热饮水机四十分钟,把冷热饮水机口打开放没水,然后把后面的排水口打开把脏水排干净。

第四步,倒入2到3次清水,用第三步的方法把水排干净,去除醋味。

建议一个月对饮水机进行消毒清洗一次奥。为了保证饮水健康,小伙伴们赶快试试吧!